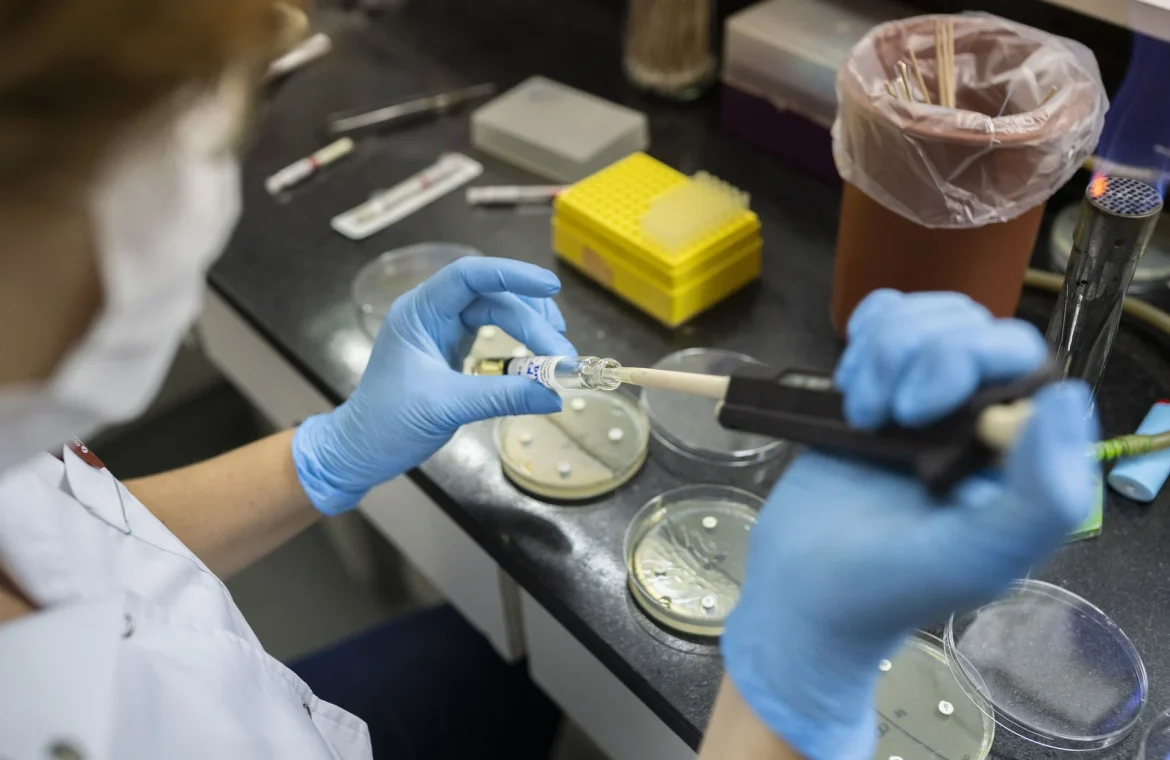

Ο γενικός διευθυντής του Παγκόσμιου Οργανισμού Υγείας (ΠΟΥ) απηύθυνε χθες, Πέμπτη, επείγουσα έκκληση να αυξηθεί η παραγωγή εμβολίων κατά της χολέρας, οι ποσότητες των οποίων είναι ανεπαρκείς το τρέχον διάστημα, δεδομένης της ζήτησής τους από δεκάδες χώρες.
«Η (υγειονομική) αντίδραση συνεχίζει να πλήττεται από την κρίσιμη έλλειψη εμβολίων», εξήγησε ο Δρ. Τέντρος Αντανόμ Γκεμπρεχέσους μέσω X.
«Η ζήτηση συνεχίζει να ξεπερνά την προσφορά, με 105 εκατομμύρια δόσεις να έχουν ζητηθεί από 18 χώρες από τον Ιανουάριο του 2023» την ώρα που «παρήχθησαν 55 εκατομμύρια δόσεις την περίοδο αυτή», εξήγησε.
Ο ΠΟΥ καλεί να γίνουν περαιτέρω επενδύσεις για να αυξηθεί η παραγωγή εμβολίων και ζητεί από όλα τα κράτη να επενδύσουν επίσης στο νερό και στα αποχετευτικά συστήματα, καθώς και στην προετοιμασία για καταστάσεις έκτακτης ανάγκης, ώστε να αποφευχθούν νέες επιδημικές εξάρσεις, πρόσθεσε ο Δρ. Τέντρος.
Λαμβανομένου υπόψη του αριθμού των ξεσπασμάτων επιδημιών και τη γεωγραφική επέκτασή τους, καθώς και την έλλειψη εμβολίων και άλλων πόρων, ο ΠΟΥ συνεχίζει να χαρακτηρίζει τον κίνδυνο σε παγκόσμια κλίμακα «πολύ υψηλό», σύμφωνα με μηνιαίο επιδημιολογικό δελτίο του για τη χολέρα που δημοσιοποίησε χθες.
Από την 1η Ιανουαρίου ως την 28η Ιουλίου, καταγράφτηκαν 307.433 κρούσματα χολέρας και 2.326 θάνατοι σε 26 χώρες, σύμφωνα με τα δεδομένα του ΠΟΥ.
Η περιοχή της ανατολικής Μεσογείου συνεχίζει να καταγράφει τους υψηλότερους αριθμούς, ακολουθούμενη από την αφρικανική περιφέρεια, αυτή της νοτιοανατολικής Ασίας, της αμερικανικής περιφέρειας και της ευρωπαϊκής περιφέρειας. Καμιά επιδημία δεν αναφέρθηκε την περίοδο αυτή στην περιφέρεια του δυτικού Ειρηνικού Ωκεανού.
Η χολέρα, η οποία μεταδίδεται μέσω μολυσμένων τροφίμων ή νερού και από μολυσμένα περιττώματα που περιέχουν το βακτήριο Vibrio cholerae, προκαλεί οξεία διάρροια και αφυδάτωση και μπορεί να επιφέρει τον θάνατο μέσα σε ώρες χωρίς θεραπεία.